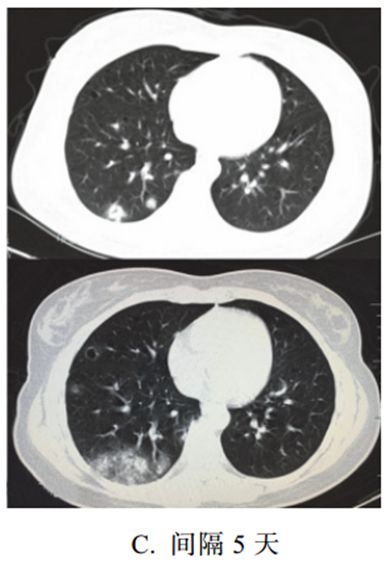
图片

这波新冠感染后“嗓子奇痒无比”?一文总结!新冠肺炎CT早期征象+鉴别诊断
2024年8月27日
病灶以肺外围背侧为主,以两肺下叶为著,与胸膜常紧贴,提示新冠肺炎病变多首先侵犯皮层肺组织的细支气管及肺泡上皮,病灶分布逐步从外周向中央扩展(图 2-1)病灶形态以三种类型为主,即多叶多灶分布病灶(图 2-2A) 、单叶片状病灶(图 2-2B)和孤立性类圆形病灶(图 2-2C)绝大多数案例出现磨玻璃病灶,最低测得 CT 值约为-600Hu(图 2-3) ,病灶内血管穿行可清晰显示;部分案例磨玻璃病灶与实性病灶共存。根据既往严重急性呼吸综合征(SARS)病理学机制,提示此为肺泡间隔毛细血管扩张充血、肺泡腔内液体渗出和小叶间隔间质水肿 图 2-3 早期绝大多数病灶表现为磨玻璃密度(共4张 )在磨玻璃病灶内部常可见细网格状阴影,类似铺路石状,称为细网格征或铺路石征(图 2-4) 。提示病理改变为小叶间隔及小叶内间隔增厚,反映间质性病变,也有的学者解析为血管网增多,符合肺部病毒感染病理特性。部分案例实性结节病灶周围出现磨玻璃密度影,边缘模糊,称为晕征。根据既往病理学机制提示,病灶中心实变影为肺泡腔内聚集大量富细胞渗出液,显示为实性密度灶;其周围肺泡亦见渗出,包含炎症细胞、蛋白质、纤维素等,形成“膜状物”,或形成磨玻璃密度阴影(图 2-5)。病灶沿着胸膜下呈长条片状分布,一般不引起胸膜反应。提示病理改变:病变首先累及皮层肺组织,不按肺段解剖分布,对细菌性肺炎病灶分布有一定的鉴别意义(图 2-6)。实变肺组织内可见含气支气管正常穿行,未见明显狭窄和扭曲,少部分病例可以看到支气管壁增厚,管腔通畅。而晚期病变可以出现支气管牵拉、扭曲征象(图 2-7)。较多病灶常沿着支气管血管束分布,从外周向中央进展亦如此表现。提示病理改变:病毒肺炎病灶常沿着间质分布蔓延(图 2-8) 。在亚实性病灶内部清晰显示血管走行,部分血管管径增粗,甚至比近端更粗。可能提示病理改变为血管周围间质水肿,并非血管内径增粗(图 2-9)。新冠肺炎早期病灶内部未见明显空洞和肺气囊形成,极少见到树芽征;双侧胸腔未见明显积液;一般未见明显纵隔淋巴结肿大(图 2-10)。新冠肺炎大多数病例进展迅速,复查 CT 影像发生明显变化。表现为病灶数目明显增多,范围明显扩大,密度增高,病灶分布由外周向中央推进。根据既往 SARS 病理学机制,提示为肺泡腔内聚集大量细胞渗出液、间质内血管扩张渗出;肺泡连通起来形成融合态势(图 2-11)。新冠肺炎肺部病变一般在发病后 14 天左右达到高峰,少部分病例急剧进展,病变累及双侧全肺,呈白肺征象,其内可见空气支气管征,双侧胸腔可有少量胸腔积液,临床纳入危重症管理。根据既往病理学机制提示肺泡腔有大量纤维素性渗出。多数病例在 14 天后进入病灶消散期,表现为病灶逐步吸收,可遗留少许条索状高密度影,提示纤维化。少部分病例病程较短,影像可由早期表现直接进入消散期(图 2-17)。根据临床观察, 20%~30%的确诊病例的 CT 影像表现不典型,无法与其他肺部病变进行鉴别(图 2-20) 。多次 CT 复查可表现为完全阴性征象,或仅表现为胸膜下小斑点影。但确诊者多次 CT 检查阴性同样具有临床意义,提示预后良好,丽水市第一例新冠肺炎出院患者肺部未见明确病灶。1. 早期病灶分布于两肺背侧胸膜下,以下叶为著,单发或双肺多发磨玻璃密度影(GGO) ,其内肺纹理可见,呈网格状(提示小叶及小叶内间质增厚) ,伴随血管增粗;部分表现为结节伴周围晕征;部分病灶长轴与胸膜平行,不按肺段分布。病灶无空洞形成,无胸腔积液,纵隔淋巴结无明显肿大。病灶内部支气管走行通畅,无明显扭曲变形,极少见到树芽征。2. 进展期病灶随着病情进展,病灶范围迅速增多扩大,沿着支气管血管束从周围向中央推进,也可呈反蝶翼状分布;病灶内密度增高或不均匀,出现实变。3. 重症期表现为大范围肺组织密度增高实变,少数呈白肺征象。4. 消散期片状 GGO 可完全吸收,肺内病灶向纤维化演变。来自援助武汉某医疗专家组总结的 14 条诊疗意见,其中关于影像内容的有 7 条,提示影像占据重要地位,供参考:1. 病毒性肺炎包括甲型流感、 SARS、新冠肺炎,在影像学上其都有亚实质性的、云雾状或者磨玻璃样改变,具有多形性特征。2. CT 检查影像学上有多形态、多部位的改变,早期为团块状影,可单肺,也可双肺,有此消彼长的特点,还有支气管充气征等表现。3. 病情变化快、恶化快,恢复期肺部阴影吸收也快,可以 2~3天变得淡薄。4. 进展期和好转期阶段与影像学不同步,常症状消失,核酸检测阴性,但影像学上却反而加重。5. 影像学检查的作用和意义很重要,尤其是在 CT 条件允许的情况下, 3~5 天要检查一次。6. 患者在没有基础疾病或一般情况还可以的情况下,可突然出现死亡,认为与炎症风暴有关,应对措施有三条:第一,抗感染;第二,使用激素,特别是症状重、有炎症渗出者应该及时提前干预,宁早勿晚,剂量宁多勿少;第三,行人工肝血浆置换,可以清除炎症因子,这个措施成功率很高。7. 如何及时观察病情是否恶化?答案是采用 CT 检查。8. 气管插管不是首选,经鼻高流量氧疗是最佳方法。9. 病情恶化的患者都在发热,尤其是第 7~14 天,无论使用什么药,病情仍进展,白细胞计数在下降,有时可降至(2~3) ×109/L,此后可出现回升,并且持续升高,呈现细菌感染的特征。抗生素的使用应该加强。10. 患者病程的平均时间为 3~4 周,第 2~3 周为高峰期,有些可以到21 天还在进展。11. 病毒传染性很强,毒力也非常强,其实不比 SARS 差。本病通常在潜伏期就有传染性,明确的传播途径有呼吸道飞沫和接触传播,并可能通过消化道、母婴和气溶胶等途径传播,有家庭聚集性特征。12. 现在的诊疗指南表明治愈的标准是两次核酸检查阴性,但是实际上第三次检查时有部分病例仍呈阳性。13. 有部分病例在潜伏期没有症状的情况下,影像学检查却呈阳性。这点要特别注意。14. 激素的使用时机可以提前,这样可以缩短病程,减轻病情。流感病毒属于正黏液病毒科的病毒种类,均为单链 RNA 病毒,并根据其内膜系统和核蛋白抗体分为三型(甲型、乙型、丙型),以甲型导致的流感病毒性肺炎常见,如 H1N1、 H5N1、 H7N9 等。疾病的早期常表现为气管支气管炎和支气管肺炎,气道壁充血,可见单核细胞肿胀和上皮细胞变性。晚期实质改变表现为弥漫性肺泡损伤的典型特征,肺泡内水肿、出血。(1)早期从一侧叶开始,进展期双肺逐渐进展,磨玻璃样、斑片状实变影快速融合(代表弥漫性肺泡损伤或双重感染)。(2)恢复期病变吸收变淡,出现条索状影、网格影(图 3-1A),背景小叶间隔增厚,以及出现肺气囊、肺气肿。(4)一般于 3 周内吸收、纤维化(图 3-1B)。腺病毒属于哺乳动物腺病毒属,为无包膜的双链 DNA 病毒。腺病毒性肺炎易发生于婴幼儿或免疫功能障碍的人群。本病起病急,高热,并发症多、(1)多呈大叶性分布(图 3-2A),实质、间质均受累。(3)显示类似细菌性肺炎的支气管肺炎征象(肺叶或节段性分布),如腺泡结节、 GGO、实变等(图 3-2B)。(4)后遗症:闭塞性细支气管炎、支气管扩张、肺纤维化、单侧透明肺等。呼吸道合胞病毒(RSV)是引起婴幼儿下呼吸道感染的最常见病毒,成人少见。在所有年龄段,人 RSV 感染都会导致细支气管炎、肺炎和哮喘。(1)病变以气道为中心进行分布,支气管周围可见小叶中心结节(图 3-3A),气腔实变,有磨玻璃样影。人鼻病毒(A、 B、 C)属于小 RNA 病毒科,是呼吸道感染的主要病原体,春季和秋季更常见,免疫功能低下的患者更容易感染,在需要入住 ICU 的重症肺炎患者中,人鼻病毒是最常见的病原体。病理机制为呼吸道上皮屏障破坏,导致血管通透性增加,黏液分泌增多。(1)合并多灶性 GGO 和小叶间隔增厚(图 3-4)。人类疱疹病毒(HSV)是一大类的 DNA 病毒,严重致病性人类疱疹病毒包括 HSV-1、 HSV-2。疱疹病毒性肺炎主要是由 HSV-1 引起的,在免疫功能低下的患者或气管插管时气道受到创伤的患者,以及烟雾吸入或慢性吸烟患者中相对常见。(1)包括斑片状肺叶、肺段或亚段性的实变影和磨玻璃样影(图 3-5A),间质分布小网格影(图 3-5B)。2003 年,严重急性呼吸综合征(SARS)冠状病毒引起的肺炎全球暴发,宿主主要来源于果子狸,潜伏期为 2~10 天,表现为类流感症状,如呼吸难,复发或持续的发热。SARS 冠状病毒通过累及血管紧张素转换酶诱导直接肺损伤,导致弥漫性肺泡损伤。其病死率较高,约 21%的患者为医护人员。(1)以下肺、单发为主,主要表现为相对清楚的 GGO,其内小血管增多、增粗(图 3-6)。中东呼吸综合征冠状病毒(MERS-CoV)是 β 冠状病毒的新成员,初次发现是在 2012 年,宿主主要来源于骆驼,临床症状与其他下呼吸道感染类似,发展迅猛,进展为急性呼吸窘迫综合征、多脏器功能衰竭等,死亡率高。(1)包括胸膜下和基底部气腔病变(图 3-7A),伴广泛的 GGO和实变(图 3-7B)。常见致病菌:肺炎链球菌、金黄色葡萄球菌、嗜肺军团菌、肺炎克雷伯菌、流感嗜血杆菌等。流行病学分类:①社区获得性肺炎,常表现为大叶性肺炎和支气管肺炎;②医院获得性肺炎。大叶性肺炎以秋冬季节多见,常见于青壮年,致病菌主要为肺炎链球菌、肺炎克雷伯菌、军团菌,常累及整个肺叶或肺段。临床表现为突然发病、畏寒发热、胸痛、咳嗽、咳痰,白细胞和中性粒细胞计数明显升高等。(1)充血期肺组织呈边缘不清的云雾状影,实变期呈大片实变影(图 3-8A)、充气支气管征(图 3-8B),消散期呈散在斑片状影。(2)肺炎链球菌肺炎与肺炎克雷伯菌肺炎的区别:前者支气管充气征清晰可见,可达胸膜下;后者因分泌物黏稠,支气管充气征显示不佳。支气管肺炎又称为小叶性肺炎,常见于婴幼儿和年老体弱者。致病菌主要为肺炎链球菌、金黄色葡萄球菌,常可为麻疹、百日咳、流感的并发症。病变以小叶支气管为中心,在支气管和肺泡内产生炎性渗出。临床表现为畏寒发热、胸痛、咳嗽、咳痰、呼吸困难等。(1)病变多分布于两肺中内带,可见沿支气管血管束分布的斑片、絮片、条索状影(图 3-9),出现树芽征。(2)病灶可融合成团片状,常伴有局限性肺气肿、肺不张。肺曲霉菌病主要是因吸入曲霉菌孢子而发病,是一种机遇性感染,为非化脓性炎症,可寄生于结核性空洞、肺癌空洞,以及慢性肺脓肿、肺囊肿、肺大疱及支气管扩张等病变所致的空洞或空腔内,少数因消化道或上呼吸道曲霉菌感染经血行播散至肺部。曲霉菌的菌丝呈游离状态,形成曲菌球。(1)典型征象为曲菌球(图 3-10)、空气半月征、手套征。(2)多样化病灶并存,可伴有晕征、空洞、洞丝征及树上挂果征。(3)曲菌球随体位改变而变化,球形内容物一般较光滑,密度均匀。肺隐球菌病的病原体为新型隐球菌,此菌为土壤、牛乳、鸽粪和水果等中的腐生菌,感染途径为吸入性。感染人群多见于 40~60岁的成人,临床症状轻,呈亚急性或慢性感染,可侵犯中枢神经系统,表现为慢性脑膜炎、脑膜脑炎或颅内压增高症状。(1)呈单发或多发斑片 、 类 圆形 或结 节 影, 多位 于 胸膜下(图 3-11)。(2)可出现小空洞、晕征,有时呈炎性肿块改变(图 3-12)。支原体肺炎是由支原体引起的以间质性改变为主的肺炎。支原体侵入肺内可引起支气管、细支气管黏膜及周围间质充血和水肿,多核细胞浸润,侵入肺泡可产生肺泡浆液性渗出炎症。病变范围可从小叶、肺段至大叶。多数患者症征不符:临床症状重,影像学表现较轻。实验室检查支原体抗体呈阳性,发病 2~3 周后血冷凝集试验比值升高(可达 1∶64)。(1) HRCT 显示更清晰,呈树雾征(图 3-13A)、树芽征(图 3-13B),可出现支气管壁增厚。卡氏肺孢子虫肺炎(PCP)是艾滋病患者最主要的机遇性感染之一。卡氏肺孢子虫引起Ⅰ型肺泡上皮细胞损害、Ⅱ型肺泡上皮细胞增生和间质性肺炎等病理改变,可导致肺间质性纤维化。临床表现为进行性呼吸困难、咳嗽、发热,病程持续数周或数月。PCP 相关检测查找卡氏肺孢子虫病原体。艾滋病患者免疫力极低,常合并其他感染,如结核、真菌等。(1)广泛或局限性磨玻璃样密度影,以肺门周围为主,有融合趋势(图 3-14A)。(2)慢性及复发的病例可引起小叶间隔增厚及网格影。(3)可出现囊性病变(图 3-14B)、自发性气胸及肺实变影。肺水肿病理上分为间质性肺水肿和肺泡性肺水肿,严重者常两种情况并存,心源性肺水肿居多。肺泡性肺水肿液体在肺泡内聚集呈片状,肺体积增大,有液体外渗,合并充血时渗液呈红色或棕色,急性期表现为气急、端坐呼吸、咳泡沫白痰或粉红色痰,可闻及湿啰音,可同时出现全身静脉压升高及肝脾大的表现。(1)典型蝶翼征(图 3-15A),两肺散布大小不等、密度不均、轮廓不清的片状模糊影(图 3-15B),局限性表现为一侧、一叶或局部的密度增高影。(2)心源性肺水肿可见双侧上肺静脉扩张,心影增大,可合并胸腔积液、心包积液。过敏性肺炎(HP)是由吸入各种抗原性有机物粒子而引起的弥漫性肉芽肿间质性肺疾病,分为急性期、亚急性期、慢性期(不同阶段可以重叠),组织学表现和影像学表现相似,与抗原类型无关。(1)双肺多发边缘模糊的小叶中心结节(图 3-16)、磨玻璃样影。肺泡蛋白沉积症(PAP)是一种比较罕见的肺部慢性疾病,分为先天性、自身免疫性及继发性,自身免疫性 PAP 多见。镜下观察细支气管和肺泡内含大量过碘酸-希夫(PAS)染色阳性的富磷脂细微颗粒,肺泡壁及间质结构正常,小叶间隔增厚。临床表现轻于影像学表现,最常见症状是气短,特别是活动后明显,部分患者的病情可自行缓解,但可复发。(1)磨玻璃样影,与正常肺组织边界清楚,其边缘呈多角形或多边形,呈地图状分布(图 3-17)。(2)弥漫细线及网格影,代表小叶内及小叶间隔增厚,磨玻璃样影及小叶间隔增厚叠加形成铺路石征或碎石路征。(4)肺间质纤维化表现为蜂窝肺及牵拉性支气管扩张,出现此表现提示预后不良。肺间质纤维化性疾病包括一系列导致肺间质进行性纤维化的原发性或继发性结缔组织疾病,原发性主要为特发性肺间质纤维化,继发性主要包括系统性红斑狼疮、干燥综合征、类风湿关节炎等。特发性肺间质纤维化、系统性红斑狼疮、干燥综合征三种病变在影像学上表现相似,属于典型的“同影异病”,均表现为肺间质纤维化改变。细菌和病毒均可以引起间质性肺炎。影像学表现:两肺支气管血管束增多,网格状及小点状影,周围夹杂多发蜂窝状囊状影、肺气肿及牵拉性支气管扩张,相应胸膜下小叶间隔增厚(图 3-18)。抗中性粒细胞胞质抗体(ANCA)相关性血管炎属自身免疫性疾病,是一种坏死性肉芽肿性血管炎。90%的患者伴有鼻窦等上呼吸道病变, ANCA 多呈阳性。该病病变累及小动脉、小静脉及毛细血管,其病理机制以血管壁的炎症为特征。临床表现多样,可累及多系统,如上呼吸道、肺和肾脏发生病变。(1)多发结节、斑片影(图 3-19),可有充气支气管征及灶性空洞,周围出现磨玻璃样影,常提示肺泡出血或梗死。(3)继发性改变,如支气管扩张或肺结构改变(如蜂窝肺)。吸入性肺炎常见于慢性衰弱性疾病、咽和食管结构异常、全身麻醉等患者。吸入性肺炎可导致肺损伤或肺部炎症性疾病,如肺内节段性肺炎、支气管肺炎、肺脓肿和脓胸等。老年人存在隐性误吸。影像学表现:无明显特异性特征,需结合病史与临床表现来做出诊断(图 3-20)。